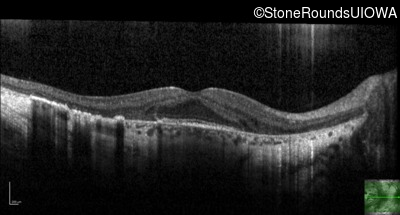
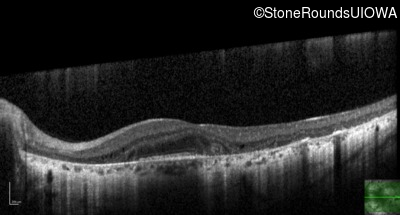
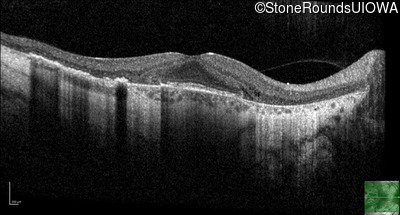
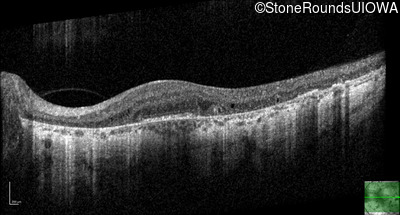

Case
SR2152
Student Mode
XL Choroideremia (IIIA1a)
Male
Male
Hidden
SR2152
Student Mode
XL Choroideremia (IIIA1a)
Male
Male
History
This 35-year-old man has trouble in low light and when moving around in busy places. He first reported trouble seeing in low light at age 13. His maternal grandfather was similarly affected.
| Age at visit: 35 years |
Diagnosis & molecular findings
| Disease | Gene | Allele 1 variant(s) | Allele 2 variant(s) | Inheritance mode |
|---|---|---|---|---|
| XL Choroideremia | CHM | Leu527 del4aaaTTGT | XL |